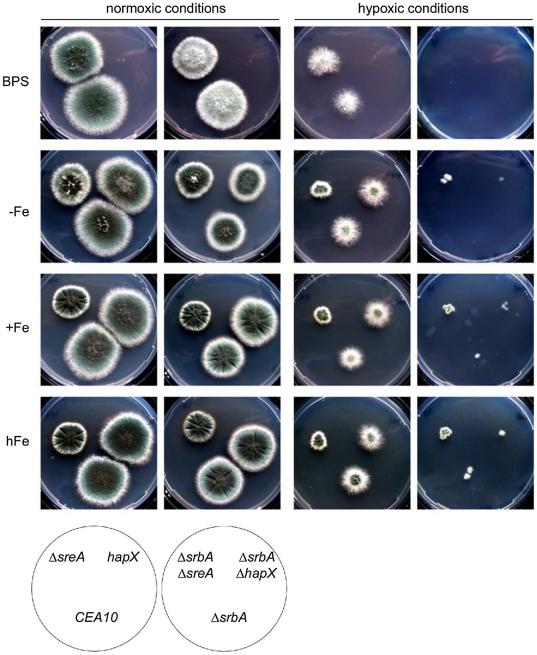
https://cdn.ncbi.nlm.nih.gov/pmc/blobs/e45c/3228822/7b6c08124291/pgen.1002374.g008.jpg

SREBP 协调铁和麦角固醇稳态来介导人类真菌病原体烟曲霉中的三唑类药物和缺氧反应。
SREBP coordinates iron and ergosterol homeostasis to mediate triazole drug and hypoxia responses in the human fungal pathogen Aspergillus fumigatus.
机构信息
Division of Molecular Biology/Biocenter, Innsbruck Medical University, Innsbruck, Austria.
出版信息
PLoS Genet. 2011 Dec;7(12):e1002374. doi: 10.1371/journal.pgen.1002374. Epub 2011 Dec 1.
Sterol regulatory element binding proteins (SREBPs) are a class of basic helix-loop-helix transcription factors that regulate diverse cellular responses in eukaryotes. Adding to the recognized importance of SREBPs in human health, SREBPs in the human fungal pathogens Cryptococcus neoformans and Aspergillus fumigatus are required for fungal virulence and susceptibility to triazole antifungal drugs. To date, the exact mechanism(s) behind the role of SREBP in these observed phenotypes is not clear. Here, we report that A. fumigatus SREBP, SrbA, mediates regulation of iron acquisition in response to hypoxia and low iron conditions. To further define SrbA's role in iron acquisition in relation to previously studied fungal regulators of iron metabolism, SreA and HapX, a series of mutants were generated in the ΔsrbA background. These data suggest that SrbA is activated independently of SreA and HapX in response to iron limitation, but that HapX mRNA induction is partially dependent on SrbA. Intriguingly, exogenous addition of high iron or genetic deletion of sreA in the ΔsrbA background was able to partially rescue the hypoxia growth, triazole drug susceptibility, and decrease in ergosterol content phenotypes of ΔsrbA. Thus, we conclude that the fungal SREBP, SrbA, is critical for coordinating genes involved in iron acquisition and ergosterol biosynthesis under hypoxia and low iron conditions found at sites of human fungal infections. These results support a role for SREBP-mediated iron regulation in fungal virulence, and they lay a foundation for further exploration of SREBP's role in iron homeostasis in other eukaryotes.
固醇调节元件结合蛋白(SREBPs)是一类基本螺旋-环-螺旋转录因子,它们调节真核生物中各种细胞反应。除了已认识到 SREBP 在人类健康中的重要性之外,新型隐球菌和烟曲霉等人类真菌病原体中的 SREBP 对于真菌的毒力和对三唑类抗真菌药物的敏感性也是必需的。迄今为止,SREBP 在这些观察到的表型中所起作用的确切机制尚不清楚。在这里,我们报告称,烟曲霉 SREBP,SrbA,介导了对缺氧和低铁条件下铁摄取的调节。为了进一步定义 SrbA 在铁摄取方面的作用,我们与之前研究的真菌铁代谢调节剂 SreA 和 HapX 进行了比较,在 ΔsrbA 背景下生成了一系列突变体。这些数据表明,SrbA 在铁限制下独立于 SreA 和 HapX 被激活,但 HapX mRNA 的诱导部分依赖于 SrbA。有趣的是,在 ΔsrbA 背景下外源添加高铁或基因删除 sreA 能够部分挽救 ΔsrbA 的缺氧生长、三唑药物敏感性和麦角固醇含量降低的表型。因此,我们得出结论,真菌 SREBP SrbA 对于协调缺氧和低铁条件下(即人类真菌感染部位)铁摄取和麦角固醇生物合成相关基因是至关重要的。这些结果支持了 SREBP 介导的铁调节在真菌毒力中的作用,并为进一步探索 SREBP 在其他真核生物中铁稳态中的作用奠定了基础。